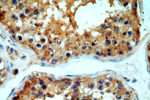
MYO16 Antibody in Immunohistochemistry (Paraffin) (IHC (P))
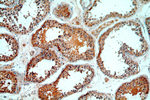
MYO16 Antibody in Immunohistochemistry (Paraffin) (IHC (P))

Search
Proteintech
MYO16 Polyclonal Antibody
{{$productOrderCtrl.translations['antibody.pdp.commerceCard.promotion.promotions']}}
{{$productOrderCtrl.translations['antibody.pdp.commerceCard.promotion.viewpromo']}}
{{$productOrderCtrl.translations['antibody.pdp.commerceCard.promotion.promocode']}}: {{promo.promoCode}} {{promo.promoTitle}} {{promo.promoDescription}}. {{$productOrderCtrl.translations['antibody.pdp.commerceCard.promotion.learnmore']}}
产品信息
18828-1-AP
种属反应
宿主/亚型
分类
类型
抗原
偶联物
形式
浓度
规格
纯化类型
保存液
内含物
保存条件
运输条件
产品详细信息
The antibody can recognize isoform 1, isoform 2 and isoform 3 of MYO16.
靶标信息
Myosins are actin-based motor molecules with ATPase activity. Unconventional myosins serve in intracellular movements. Their highly divergent tails are presumed to bind to membranous compartments, which would be moved relative to actin filaments. May be involved in targeting of the catalytic subunit of protein phosphatase 1 during brain development. Activates PI3K and concomitantly recruits the WAVE1 complex to the close vicinity of PI3K and regulates neuronal morphogenesis.
仅用于科研。不用于诊断过程。未经明确授权不得转售。
篇参考文献 (0)
生物信息学
蛋白别名: myo16; MYO16 variant protein; myosin heavy chain Myr 8; myosin-XVI; neuronal tyrosine phosphorylated adaptor for phosphoinositide 3-kinase adaptor 3; Neuronal tyrosine-phosphorylated phosphoinositide-3-kinase adapter 3; neuronal tyrosine-phosphorylated phosphoinositide-3-kinase adaptor 3; protein phosphatase 1, regulatory subunit 107; Unconventional myosin-16; Unconventional myosin-XVI; unnamed protein product
基因别名: BM140241; C230040D10Rik; Gm1105; KIAA0865; mKIAA0865; MYAP3; MYO16; MYO16B; MYR8; NYAP3; PPP1R107
UniProt ID: (Human) Q9Y6X6, (Mouse) Q5DU14
Entrez Gene ID: (Human) 23026, (Mouse) 244281